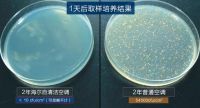
中科院细菌实验揭秘：夏天不敢乱开空调，原因都在这了

2020-06-05
6月2日,山东省气象台发布今年首个高温黄色预警,预计未来三天,全省多个城市的部分地区最高气温可达37℃以上。高温季来临,许多家庭面临着这样的疑惑: 家里空调能开吗?开空调会存在防疫隐患吗? ...
>> 查看全文
2020-06-05
6月4日,由海尔空调牵头的2019年度山东省重大科技创新工程"新型云-边缘模式智能制造管控平台及应用示范"项目启动会在青岛召开,来自青岛海尔空调器有限总公司、青岛海尔(胶州)空...
>> 查看全文
[家居服] 【德叔课堂】贴完砖马上美缝,可吗?
2020-06-05
早前,岳阳董先生说,新居那边正要进行贴砖施工,而自己又比较忙,想贴完砖后马上安排进行美缝施工,问德叔这样可以不?另外就是,新居的瓷砖缝隙感觉有点深,能不能先用其他填缝料填一半,再用美瓷胶填缝? ...
>> 查看全文
2020-06-05
上海市商务委副主任刘敏6月3日在上海市政府新闻发布会上表示,“五五购物节”期间,上海交家电行业协会组织苏宁、国美、永乐3家连锁企业,以及32个知名家电品牌在沪销售公司,开展 “以旧换新”促...
>> 查看全文
2020-06-05
进入6月,伴随着炎炎夏日到来的是永恒不变的“空调热”。以往这个季节都是各空调品牌的“丰收季”;而今年,伴随着“史上最严”新国标正式实施的时间——7月1日越来越近,空调市场可谓喜忧参半。现有的低能效、...
>> 查看全文